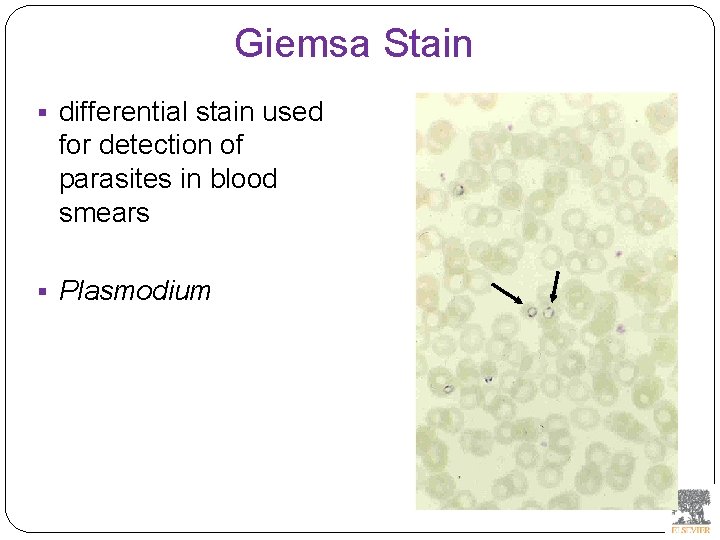
Giemsa Stain § differential stain used for detection of parasites in blood smears §

YEDTEPE UNIVERSITY YEDTEPE SCHOOL OF MEDICINE Laboratory Diagnosis

YEDİTEPE UNIVERSITY YEDİTEPE SCHOOL OF MEDICINE Laboratory Diagnosis of Infectious Diseases –II (Examplary Methods and Tests) (Modified from the lecture given by Prof. Gülden Çelik, 2015 -2016)

Laboratory Methods in Clinical Microbiology • Direct: • -Microscopy • -Culture • -Antigen • -Nucleic acid • Indirect: • -Specific antibody (Serology) (Ig. G, Ig. M, Ig. A)

Microscopy Two basic purposes: 1 -the initial detection of microbes 2 -the preliminary or definitive identification of microbes. The microscopic examination of clinical specimens is used to detect: • bacterial cells, • fungal elements, • parasites (eggs, larvae, or adult forms), and • viral inclusions present in infected cells. Characteristic morphologic properties can be used for the preliminary identification of • most bacteria and • are used for the definitive identification of many fungi and parasites. • But lacks sensitivity !

Microscopy • • • Brightfield (light) microscopy Darkfield microscopy Phase-contrast microscopy Fluorescent microscopy Electron microscopy

Microscopy • Darkfield microscopy (Treponema pallidum) Treponema pallidum in the direct fluorescent antibody test : more sensitive and specific The microscopic detection of organisms stained with antibodies labeled with fluorescent dyes or other markers: • very useful for the direct, sensitive and specific identification of many organisms.

Microscopy Direct Fluorescent Stains (without antibody marker) • Acridine orange stain: • Used for detection of bacteria and fungi in clinical specimens. • Auramine-rhodamine stain: • Same as acid-fast stains. • Calcofluor white stain: • Used to detect fungal elements and Pneumocystis spp. Direct fluorescent antibody stain • Antibodies (monoclonal or polyclonal) are complexed with fluorescent molecules. • Specific binding to an organism is detected by presence of microbial fluorescence. • Technique has proved useful for detecting or identifying many organisms • (e. g. , Streptococcus pyogenes, Bordetella, Francisella, Legionella, Chlamydia, Pneumocystis, Cryptosporidium, Giardia, influenza virus, Herpes simplex virus). • Sensitivity and specificity of the test are determined by • the number of organisms present in the test sample and quality of antibodies used in reagents.


Microscopy Other Direct Examination Microscopy Methods • The sample: • can be suspended in water or saline (wet mount), • mixed with alkali to dissolve background material (potassium hydroxide [KOH] method) : fungal elements • mixed with a combination of alkali and a contrasting dye (e. g. , lactophenol cotton blue: fungal elements • mixed with Lugol iodine: • Iodine is added to wet preparations of parasitology specimens to enhance contrast of internal structures. • Facilitates differentiation of protozoa and host white blood cells.

Enterobius vermicularis § Pinworm eggs are deposited by adults at night in the perianal area. § Eggs are collected by pressing tape on the anal surface and examining it microscopically. § Eggs appear as an embryo surrounded by a colorless shell that is characteristically flattened on one side. 9

Microscopy Other Direct Examination Microscopy Methods • The sample: • mixed with India ink • in which the ink darkens the background rather than the cell. • used to detect capsules surrounding organisms, • the yeast Cryptococcus (the dye is excluded by the capsule, creating a clear halo around the yeast cell), • is a rapid method for the preliminary detection and identification of this important fungus.

Microscopy Most organisms are colorless and transparent, various dyes (stains) are used to see the individual cells A variety of different types of stains are used in the microbiology lab, including: • Contrast stains • (e. g. , methylene blue, lactophenol cotton blue, India ink, iodine) • Differential stains • (e. g. , Gram stain, spore stains, acid-fast stains, Giemsa stain, silver stains, Trichrome stain) • Fluorescent stains • (e. g. , acridine orange, auramine-rhodamine, calcofluor white, antibodyconjugated fluorescent stains)

Microscopy • Differential stains • (e. g. , Gram stain, spore stains, acid-fast stains, Giemsa stain, silver stains, Trichrome stain) • Gram stain : • -bacteria (positive, negative) • -yeasts (yeasts are gram-positive). • Iron hematoxylin and trichrome stains: • protozoan parasites • Giemsa stain: • blood parasites and other selected organisms



Methylene Blue Stain § Corynebacterium diphtheriae

Lactophenol Cotton Blue (LCB) Stain § primarily for observing the morphology of fungal molds : Aspergillus

India Ink Stain § The India ink stain: § negative contrasting stain § Cryptococcus neoformans. § The ink is excluded by the fungal capsule so the fungi (arrows) are unstained and surrounded by a clear halo, while the ink particles provide a background contrast.

Iodine Stain § The iodine stain is a contrast stain used primarily for the detection of intestinal parasites (Entamoeba coli in this example).

Gram Stain § gram-positive (purple) § from gram-negative (red) bacteria.

Staphylococcus aureus and Candida albicans § S. aureus (black arrow) and § yeasts, in this case Candida albicans (red arrow). § Yeast can appear as gram-positive, although they tend to decolorize readily. 20

Acid-Fast Stains § Ziehl-Neelsen stain: Used to stain mycobacteria and other acid -fast organisms. § Kinyoun stain: Cold acid-fast stain (does not require heating) § Mycobacteria § partially acid-fast organisms such as Nocardia

Microscopy • Auramine-rhodamine: • Same principle as other acid-fast stains, except that fluorescent dyes (auramine and rhodamine) are used for primary stain • Modified acid-fast stain: • Weak decolorizing agent is used with any of three acid-fast stains listed. • Whereas mycobacteria are strongly acid-fast, other organisms stain weaker (e. g. , Nocardia, Rhodococcus, Tsukamurella, Gordonia, Cryptosporidium, Isospora, Sarcocystis, and Cyclospora). • Organisms that retain this stain are referred to as partially acid-fast.

Panels A and B, Cryptosporidia. Panel C, Cyclospora. Panel D, Isospora. 23
Giemsa Stain § differential stain used for detection of parasites in blood smears § Plasmodium

Silver Stain § Silver stains are primarily used in anatomic pathology labs and not in microbiology labs. § Fungal elements (hyphae [photo] and cells) are stained with silver particles. .

Fecal leucocyte negative Fecal leucocyte positive

Culture (in vitro; on artificial media or living cells) Anton van Leeuwenhoek : Microscobic observation (1676 ) Pasteur: culture of bacteria almost 200 years later • Other rapid tests replaced culture methods • microbial antigen detection • nucleic-acid-based assays • But the ability to grow microbes in the laboratory remains an important procedure in all clinical labs. • For many diseases, the ability to grow a specific organism from the site of infection is the definitive method to identify the cause of the infection.

Culture (in vitro; on artificial media or living cells=cell culture) • The success of culture methods is defined by: • • the biology of the organism the site of the infection the patient's immune response to the infection the quality of the culture media • Culture media can be subdivided into four general categories: • enriched nonselective media, • differential media, and • specialized media • Certain bacteria need special conditions: • Legionella is an important respiratory pathogen; media should be supplemented with iron and L-cysteine. • Campylobacter, an important enteric pathogen, highly selective media should be incubated at 42° C in a microaerophilic atmosphere. • Chlamydia, an important bacterium responsible for sexually transmitted diseases, is an obligate intracellular pathogen that must be grown in living cells.

Culture (in vitro; on artificial media or living cells=cell culture) Some bacteria and all viruses are strict intracellular microbes • They can only grow in living cells. • In 1949, Enders described a technique for cultivating mammalian cells for the isolation of poliovirus. • This technique has been expanded for the growth of most strict intracellular organisms. • Cell culture is not a routine test! • The cell cultures can either be cells • that grow and divide on a surface (i. e. , cell monolayer) or • grow suspended in broth. • Some cell cultures are well established and can be maintained indefinitely. • These cultures are commonly commercially available. • Other cell cultures must be prepared immediately before they are infected with the bacteria or viruses and cannot be maintained in the laboratory for more than a few cycles of division (primary cell cultures).

Serologic Methods (Immunologic techniques) Detect Identify Quantitate antigen or antibody Disadvantage: Cross reaction -similar or common epitope

Serologic, Serodiagnosis, Serology Detection of antigen or antibody in serum The term serologic is used also for searching antigen or antibody in mediums other than serum(saliva, urine) Serologic assay=immunoassay

Immunoassays Antigen or antibody is detected In a variety of clinical specimens: Mostly sera Body fluids(cerebrospinal fluid) Tissues Environmental substances

Antibodies Polyclonal: Heterogeneous antibody preparations Recognizes many epitopes on a single antigen Monoclonal: Recognize individual epitoses on an antigen

Methods of detection Antibody-antigen complexes can be detected: Directly Labelling the antibody or the antigen: -enzyme -radioactive -fluorescent dye

Classical serologic methods Precipitation Immunodiffusion techniques Agglutination Other serologic methods Complement fixation Hemagglutination inhibition Neutralization

Agglutination tests Clumping of antigen with its antibody Flocculation: similar to agglutination; except that agglutinats float rather than sediment Prozone reaction: high antibody causes false negative. The sera should be diluted!! Antigens passively absorbed on carriers: passive agglutination

Agglutination tests Antigens passively absorbed on carriers: passive agglutination -Red blood cells: passive hemagglutination -gelatin particles: particle agglutination Classical agglutination in test tubes: -Salmonella: Gruber Widal -Brucella: Wright -Rickettsiae: Weil-Felix reaction

Agglutination negative

Agglutination positive

Precipitation Tubes: solutions Gels: Double diffusion-Quchterlony Radial immunodiffusion Countercurrent electrophoresis (pyogenic meningitis and fungal infections)

Immunoassays Immunofluorescence (IFA) Enzyme-linked immunosorbant assay (ELISA) -Western blot Radioimmunoassay (RIA)

Serology can be used to identify the infecting agent evaluate the course of an infection, or determine the nature of the infection-whether it is a primary infection or a reinfection, and whether it is acute or chronic. Serologic testing is used to identify viruses and other agents that are difficult to isolate and grow in the laboratory or that cause diseases that progress slowly

In the diagnosis of infectious diseases by immunoassays Either spesific antigen: Directly from specimen From the culture for identification Specific antibodies are detected: Ig. G Ig. M Ig. A

Specific antibody detection Seroconversion occurs when antibody is produced in response to a primary infection. Ig. M: early in infection (2 -3 weeks) transient (3 -6 months) *sometimes persists longer Ig. G: later highest in 4 -6 months usually persists during the whole life Ig. G avidity: High: past infection Low: new infection













Examples of Viruses Diagnosed by Serology Epstein-Barr virus Rubella virus, Measles, Mumps Hepatitis A, B, C, D, and E viruses Human immunodeficiency virus Human T-cell leukemia virus Arboviruses (encephalitis viruses)

Diagnosis of acute infection By specific Ig. M detection by ELISA: HAV Measles Rubella Mumps Parvovirus B 19 Varicella zoster…


Rapid antigen assay Sensitivity ! Specificity !

Quantitative antibody detection: Anti-HBs: 10 m. IU/ml Rubella Ig. G: 10 -15 IU/ml

Molecular Diagnosis Like the evidence left at the scene of a crime, the DNA (deoxyribonucleic acid), RNA (ribonucleic acid), or proteins of an infectious agent in a clinical sample can be used to help identify the agent. In many cases the agent can be detected and identified in this way, even if it cannot be isolated or detected by immunologic means. New techniques and adaptations of older techniques are being developed for the analysis of infectious agents.

Molecular methods in infectious diseases Target molecule DNA RNA

Molecular Diagnosis The advantages of molecular techniques: their sensitivity Specificity safety. . But expensive for the time being!

P C R olymerase hain eaction

PCR The polymerase chain reaction (PCR): amplifies single copies of viral DNA millions of times over one of the newest techniques of genetic analysis a sample is incubated with - two short DNA oligomers, termed primers, that are complementary to the ends of a known genetic sequence within the total DNA - a heat-stable DNA polymerase (Taq or other polymerase obtained from thermophilic bacteria) - nucleotides, and buffers.

PCR The oligomers hybridize to the appropriate sequence of DNA and act as primers for the polymerase, which copies that segment of the DNA. The sample is then heated to denature the DNA (separating the strands of the double helix) and cooled to allow hybridization of the primers to the new DNA. Each copy of DNA becomes a new template. The process is repeated many (20 to 40) times to amplify the original DNA sequence in an exponential manner. A target sequence can be amplified 1, 000 -fold in a few hours using this method. This technique is especially useful for detecting latent and integrated virus sequences, such as in retroviruses, herpesviruses, papillomaviruses, and other DNA viruses.

What is PCR? PCR uses the DNA replication ‘machinery’ of a cell to make multiple copies of a specific DNA sequence. PCR is perhaps the most successful technique in Biology PCR can take a trace amount of DNA and make enough copies of it for testing

What is it used for? PCR is useful in any situation where a small amount of DNA is insufficient for analysis. PCR is used to establish blood relationships, to identify remains, and to help convict criminals or exonerate the falsely accused. PCR is an essential procedure in any genetics laboratory.

History Discovered in 1983 in California by Kary Mullis Published in a 1985 paper Sold by Cetus Corporation for $300 million Mullis won the 1993 Nobel Prize in Chemistry for his discovery

Jonas Salk statement about his Polio vaccine: “There is no patent. Could you patent the sun? ”

How it works… Number of amplified pieces = 2 n (n = # of cycles)


The Thermocycler

Postamplification detection Gel analysis Colorimetric microtitre plate system Target amplification and detection systems occur simultaneously in the same tube (Real- Time PCR)

RV 12 İnfluenza A

Rapid real –time PCR

Other amplification methods TAS: transcription-based amplification system 3 SR: self sustained sequence replication NASBA: nucleic acid sequence-based amplification (very similar)

Other amplification techniques (II) LCR : ligase chain reaction b. DNA: branched DNA Qbeta replikase

Molecular Techniques Technique Purpose Clinical Examples RFLP: Comparison of DNA Molecular epidemiology, HSV-1 strains DNA electrophoresis: Comparison of DNA Viral strain differences (up to 20, 000 bases) Pulsed-field gel electrophoresis: Comparison of DNA (large pieces of DNA) Streptococcal strain comparisons In situ hybridization: Detection and localization of DNA sequences in tissue Detection of nonreplicating DNA virus (e. g. , cytomegalovirus, human papillomavirus) Dot blot Detection of DNA sequences in solution Detection of viral DNA

Southern blot: Detection and characterization of DNA sequences by size Identification of specific viral strains Northern blot: Detection and characterization of RNA sequences by size Identification of specific viral strains PCR: Amplification of very dilute DNA samples Detection of DNA viruses RT-PCR: Amplification of very dilute RNA samples Detection of RNA viruses

Real-time PCR: Quantification of very dilute DNA and RNA samples Quantitation of HIV genome: virus load Branched-chain DNA: Amplification of very dilute DNA or RNA samples Quantitation of DNA and RNA viruses Antibody capture solution hybridization DNA assay: Amplification of very dilute DNA or RNA samples Quantitation of DNA and RNA viruses SDS-PAGE: Separation of proteins by molecular weight Molecular epidemiology of HSV

Direct sequencing Combination of PCR with dideoxynucleotide chain termination methods can be used to determine sequence of DNA: detecting microorganisms Genotyping of viruses Identification of bacteria and fungi Antimicrobial susceptibilty testing to detect mutations


DNA microarrays Thousands of oligonucleotides are on a solid support A labelled amplification product is hybridized to the probes

Microarray

Multiplex PCR:

Now more often: !!!! -antigen detection -rapid real-time PCR -multiplex PCR

The success of the Microbiology laboratory Quality of the specimen The way its sent The method used The interpretation: Do not hesitate to have contact with your microbiology laboratory!
- Slides: 89